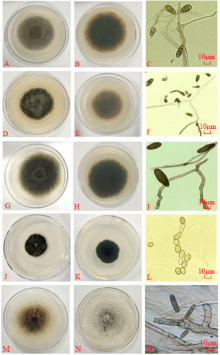

作者简介:聂秀美(1993-),女,甘肃武威人,在读硕士。E-mail: 1535946268@qq.com
为了明确甘肃省燕麦主产区叶斑病的发生情况及其病原种类,为防治提供理论依据。对定西市通渭县、张掖市山丹县和民乐县、武威市天祝县和甘南州合作市大面积种植的燕麦田间叶斑病发病情况进行了调查,对采集的病叶进行了病原菌的培养、分离、致病性测定及鉴定。结果表明,不同区域燕麦叶斑病的发生情况存在明显差异,其中定西市通渭县最严重,平均病叶率为96.15%,平均病情指数为70.26;武威市天祝县的叶斑病病叶率和病情指数分别为95.07%和69.16;张掖市民乐县叶斑病较轻,平均病叶率为8.78%,病情指数为2.45。分离纯化获得的真菌经致病性测定后发现发病症状与田间病害症状一致,经再次分离可得到相同的病菌。进一步通过形态学观察和rDNA-ITS序列分析表明引起甘肃省燕麦主产区叶斑病的病原菌有10种,分别为燕麦内脐蠕孢( Drechslera avenae)、燕麦核腔菌( Pyrenophora avenae)、德氏霉菌( Pyrenophora chaetomioides)、细交链格孢( Alternaria alternata)、芸薹链格孢( Alternaria brassicae)、苹果链格孢( Alternaria mali)、麦根腐平脐蠕孢( Bipolaris sorokiniana)、芽枝状枝孢菌( Cladosporium cladosporioides)、多主枝孢( Cladosporium herbarum)和黑附球菌( Epicoccum nigrum),优势菌为燕麦内脐蠕孢和细交链孢,在各调查样地均能分离出。明确了燕麦叶斑病在甘肃省主要种植区的发生情况及其病原种类,除燕麦内脐蠕孢和燕麦核腔菌外,其他均为国内燕麦叶斑病新的病原菌。
This study aimed to clarify the occurrence and pathogenic species causing oat leaf spot in the main oat producing areas of Gansu Province, and provide a theoretical foundation for prevention and control of this disease. Occurrence of oat leaf spot was investigated, and leaves were collected from the field for isolation, culture, pathogenicity testing, and pathogen identification. Collection locations included Tongwei County of Dingxi City, Shandan and Minle Counties of Zhangye City, Tianzhu County of Wuwei City, and Gannan County of Hezuo City. Regional differences in the occurrence of oat leaf spot were found. The occurrence was the most serious in Tongwei County of Dingxi City, where the mean leaf incidence was 96.15% and the average disease index was 70.26. Moderate leaf spot incidence and disease index (95.07% and 69.16, respectively) were recorded in Tianzhu County of Wuwei City. A relatively light occurrence was observed in Minle County of Zhangye City, where the leaf incidence was 8.78%, and the disease index was 2.45. Disease symptoms induced by the isolated and purified fungi were the same as the symptoms in the field after the pathogenicity test, and the same fungi could be obtained after re-isolation. Further morphological observation and rDNA-ITS sequence analysis indicated that a total of 10 pathogens caused oat leaf spot in the different localities where samples were collected. These were Drechslera avenae, Pyrenophora avenae, Pyrenophora chaetomioides, Alternaria alternata, Alternaria brassicae, Alternaria mali, Bipolaris sorokiniana, Cladosporium cladosporioides, Cladosporium herbarum and Epicoccum nigrum. The dominant fungi were D. avenae and A. alternata. This study clarified the occurrence and identity of pathogenic species causing oat leaf spot in Gansu Province. With the exception of D. avenae and P. avenae, the identified pathogens have, to our knowledge, not previously been reported as causes of domestic oat leaf spot.
燕麦(Avena sativa)是禾本科燕麦属一年生草本植物, 在世界五大洲的42个国家均有分布[1, 2], 具有独特的营养价值、生态价值和医疗价值等[3, 4]。此外, 燕麦还具有草籽兼用、生产潜力大、生态适应性广、加工方式多样等优点, 常用于畜牧业生产、改善生态环境和优化产业结构等[5, 6, 7]。随着人们对燕麦多方面价值认识的提高和燕麦产品的多元化, 国内外燕麦市场的需求量逐年递增, 种植面积急剧扩大。但近年来, 病害问题已经成为影响燕麦生产的主要生物因素。其中, 燕麦叶斑病在世界大多数燕麦种植区普遍发生, 具有发病范围广、时间长、为害重等特点[8], 在苗期可导致幼苗生长缓慢甚至死亡[9], 成株期可引起叶片枯萎、碳氮代谢紊乱和光合效能下降等[10], 严重影响燕麦的健康生长、品质和产量。
目前, 国内外关于燕麦叶斑病的研究报道较少。Mehta[11]对巴西巴拉那州采集的燕麦叶斑病病样进行形态学观察、分子生物学鉴定和致病性检测表明引起该地燕麦叶斑病的病原菌为燕麦内脐蠕孢(Drechslera avenae)和燕麦核腔菌(Pyrenophora avenae)。Jalli等[12]对芬兰地区的燕麦叶斑病进行研究表明, 其田间发病率为25%~63%, 病原菌为德氏霉菌(Pyrenophora chaetomioides)和禾旋孢腔菌(Cochliobolus sativus)。Má rcia等[13]研究表明, 引起巴西燕麦田叶斑病的主要病原菌为德氏霉菌, 对该病原菌的抗性成分进一步评价筛选表明, 初始病斑大小、最终病斑大小、病斑扩展率和病斑扩展面积均与燕麦叶斑病的发生具有相关性, 其中最终病变大小可作为评价燕麦品种对叶斑病抗性强弱的重要标准。袁军海等[14]对冀西北地区的51个燕麦主栽品种进行叶斑病调查, 发现该病在当地发生范围广泛, 病叶率在90%以上的品种占84.31%, 病叶率100%的品种占52.94%, 病情指数为20.31~84.87, 由叶斑病引起的减产率为5%~10%, 重者可达30%以上。刘万友[8]对不同栽培方式下燕麦叶斑病的发生情况和不同杀菌剂的防治效果研究表明, 播期对该病害的影响最大, 其次是播种密度、施磷肥量、燕麦品种和灌水量, 施氮肥量的影响最小, 且用40%的多菌灵对燕麦叶斑病的防效较好。孙雪梅[15]于2012年对华北地区的8个主栽燕麦品种的叶斑病进行了调查, 发现不同地区的发病情况存在明显差异, 内蒙古武川县和山西右玉县的发病情况相对较轻, 平均病情指数分别为10.84和11.60; 内蒙古乌兰察布市次之; 河北张北县的发生程度较重, 平均病情指数49.78。鉴定出两种致病菌燕麦内脐蠕孢和燕麦核腔菌。甘肃省是我国燕麦生产大省, 每年种植面积八万多h
于2018年7月对甘肃省定西市通渭县老站村(105° 02' E, 35° 41' N)、张掖市山丹县军马二场(101° 13' E, 38° 13' N)、张掖市民乐县炒面庄村(100° 93' E, 38° 25' N)、武威市天祝县黑马圈河村(103° 40' E, 37° 17' N)和上泉村(103° 42' E, 37° 20' N)、甘南州合作市香拉村(102° 88' E, 35° 11' N)大面积种植的燕麦田间叶斑病发生情况进行调查。每个点选两个主栽品种, 每品种随机选取3块样地, 采用对角线5点取样法, 每点随机调查50片叶, 逐叶记录病叶数和发病严重度, 并参照袁军海等[14]的计算方法和分级标准计算燕麦叶斑病的病叶率和病情指数。病级划分标准见表1。
病叶率=(发病叶片总数/调查叶片总数)× 100%
病情指数计算公式:
| 表1 燕麦叶斑病病级划分标准 Table 1 The classification standard of oat leaf spot |
1.2.1 病害样本采集 在各调查样地点采集中央呈褐色至红褐色的椭圆形或不规则形病斑、边缘褐色至黄褐色、带有黄色晕圈的病叶, 分装于标本袋内带回实验室, 经阴干后室温压制保存。
1.2.2 真菌的分离和纯化 将采集的燕麦病叶经清水冲洗, 用解剖刀刮取病斑组织进行镜检确认后, 在超净工作台用70%酒精消毒1 min, 5%次氯酸钠溶液消毒5 min, 无菌水冲洗4次, 用灭菌滤纸吸干表面水分。自然风干后, 切取病害部位5 mm的组织块置于PDA(potato dextrose agar)培养基(马铃薯200 g、葡萄糖20 g、琼脂粉15 g、蒸馏水1000 mL, 含卡那霉素和硫酸链霉素各100 mg· L-1)上, 每皿5块, 重复4次, 在25 ℃培养箱中黑暗培养。每天观察, 及时挑取菌丝至新鲜PDA培养基上分离和纯化菌落, 纯化后的菌株于-20 ℃保存备用。
参照李彦忠等[17]和雷恒树等[18]的方法作适当改进后进行致病性测定。选取健康饱满的燕麦种子用1%次氯酸钠溶液消毒10 min, 无菌水冲洗4次后播种在装有灭菌营养土的花盆, 每盆10粒, 生长3周后, 每盆留苗6株。将置于摇床中25 ℃、180 r· min-1培养1周后的孢子悬浮液经双层灭菌纱布过滤后, 加无菌水配制成1× 106个· mL-1的孢子悬浮液进行喷雾接种, 每个菌株3盆重复, 以接种无菌水为对照。所有接种叶片置于25 ℃培养箱(14 h黑暗/10 h光照, 湿度95%/75%), 用透明塑料袋覆盖保湿48 h后恢复正常管理, 第7天时对发病叶片再次进行病原菌的分离, 并确认接种前后致病菌是否相同。
参考张中义等[19]和邵力平等[20]的相关著作, 在显微镜下观察PDA平板上25 ℃暗培养7 d后的菌落形态, 并挑取分生孢子用无菌水制作水装片, 观察孢子的形态特征, 进行真菌的初步鉴定。
将菌株在PDA培养基纯化培养7 d后, 参照真菌基因组Omega试剂盒(广州飞扬生物工程有限公司)的DNA提取说明书进行病原菌DNA的提取, 并利用真菌ITS(internal transcribed spacer)通用引物对ITS1(5'-TCCGTAGGTGAACCTGCGG-3')和ITS4(5'-TCCTCCGCTTATTGATATGC-3')进行扩增, 反应体系为50 μ L:2× Taq PCR Master Mix溶液25 μ L、10 μ mol· L-1引物各1 μ L、模板5 μ L、ddH2O 19 μ L。反应程序为:94 ℃预变性5 min; 94 ℃变性30 s, 52 ℃退火30 s, 72 ℃延伸1 min, 34个循环; 72 ℃终延伸7 min。将PCR产物经电泳检测后送样进行测序, 测序结果与GenBank库中的核酸序列进行同源性比对, 并通过MEGA 7.0软件以邻接法进行菌株的亲缘关系分析。
采用Microsoft Excel 2010进行数据整理, DNASTAR软件进行序列拼接、校对, MEGA 7.0软件构建系统发育树。
通过对甘肃省5个燕麦主产区的叶斑病进行调查发现, 该病害在各调查区域普遍存在。主要危害燕麦叶片, 其成株期田间病症情况如图1所示, 病斑中央呈褐色至红褐色的椭圆形或不规则形病斑, 大小为(3~9) mm× (1~7) mm, 边缘带褐色至黄褐色, 并带有黄色晕圈。随着病情加重, 病斑会逐渐扩大, 严重时融合成片, 导致叶片变色、萎蔫。
由表2可知, 不同地区燕麦叶斑病的发病率和病情指数存在明显差异, 通渭华家岭镇老站村、天祝松山镇黑马圈河村和合作卡加曼乡香拉村的6个燕麦品种叶斑病发生情况较严重, 其病叶率为92.78%~99.61%, 病情指数为36.72~76.51。其中华家岭镇老站村的发病情况最重, 平均病叶率为96.15%, 病情指数为70.26; 松山镇黑马圈河村与之相近; 卡加曼乡香拉村的平均病叶率较高, 为99.58%, 但病情指数相对较低, 为47.91。张掖市4个燕麦品种的叶斑病害情况发生较轻, 病叶率为5.46%~34.57%, 病情指数为1.36~10.53, 其中马营乡军马二场的平均病叶率为25.35%, 病情指数为7.96; 南丰乡炒面庄村平均病叶率为8.78%, 病情指数为2.45。同一地区不同燕麦品种的发病情况不同, 南丰乡炒面庄村加拿大北燕麦(12.09%, 3.53)的发病情况也较重于玉麦子(5.46%, 1.36); 卡加曼乡香拉村的贝勒和加燕2号的病叶率相近, 但二者的病情指数差异较大; 松山镇黑马圈河村的定引1号和甜燕麦的病叶率也相近, 但前者的病情指数较大。同一品种在不同地区的病害发生程度也存在差异, 白燕7号在华家岭镇老站村的发病程度(98.67%, 71.08)明显高于马营乡军马二场(34.57%, 10.53)。
| 表2 甘肃省燕麦主产区叶斑病发生情况 Table 2 The occurrence of oat leaf spot in main producing areas of Gansu Province |
对分离纯化获得的具有形态差异的菌株进行致病性测定后发现, 共有10种不同的真菌分离物对燕麦叶片具有致病性, 将这些病原菌株编号为OL-1~OL-10, 部分病原菌接种后的症状如图2所示。其中接种第5天, 燕麦叶片开始凸显病斑, 随着时间的推移, 病斑面积不断扩大, 接种部位出现褪绿现象, 浅褐色病斑逐渐浮现, 对照组未见发病; 接种后第10天(图2), 发病症状明显加重, 其引发的叶斑病病症跟田间症状一致, 病斑中央颜色较深, 呈褐色或红褐色, 边缘浅褐色, 具黄色晕圈, 其中菌株OL-1、OL-2 OL-7的接种部位出现干枯现象, 说明其致病性较强; 其次是菌株OL-3、OL-4、OL-9、OL-10; 菌株OL-5、OL-6、OL-8的致病性较弱, 对照组未发病。从这些病斑上再次分离病原菌进行培养, 镜检发现所得的分离物与接种病原菌一致。进一步对这些再分离病原菌进行分子鉴定, 发现和待测病原菌为相同菌株, 表明这10株菌株可诱发燕麦叶斑病。
经分离纯化的病原菌在PDA培养基培养7 d后, 观察和描述其菌落形态和分生孢子形态特征, 部分菌落和孢子形态如图3所示。
菌株OL-2(图3A~C)生长速度较快, 在PDA培养基上生长7 d后, 菌落稍隆起, 近似圆形, 直径约61 μ m, 表面绒状, 中间颜色较深, 呈深褐色, 边缘整齐, 呈浅褐色, 背面具有同心圆, 中间黑褐色, 边缘黄褐色。分生孢子单生, 倒梨形或倒棒状, 黄褐色, 大小为(13.3~24.5) μ m× (3.4~10.6) μ m, 具横膈膜3~10个, 纵隔膜0~5个。根据菌株OL-2的形态特征, 初步将其鉴定为芸薹链格孢(Alternaria brassicae)。
菌株OL-3(图3D~F)生长速度适中, 生长7 d后, 菌落稍隆起, 呈不规则圆形, 直径约56 mm, 表面绒状, 中间颜色较深, 呈墨绿色, 边缘颜色较浅, 背面具有同心圆, 中间深棕色, 边缘浅棕色。分生孢子单生或串生, 倒梨形、近卵状或倒棒状, 褐色至暗褐色, 具横隔2~7个, 纵斜隔膜0~4个, 大小为(8.3~14.5) μ m× (2.4~7.6) μ m。根据形态特征, 初步鉴定为苹果链格孢(Alternaria mail)。
菌株OL-4(图3G~I)生长速度快, 生长7 d后, 菌落平铺, 近似圆形, 直径约60 mm, 表面絮状, 呈灰绿色, 边缘不规则, 背面深绿色, 边缘灰褐色, 有放射状轮纹。分生孢子单生或串生, 长椭圆形、卵形或棒球形, 中部最宽, 两端渐细, 端部钝圆, 橄榄灰色至橄榄褐色, 大小为(18.1~30.7) μ m× (7.2~11.5) μ m, 具有2~6个横隔膜, 0~3个纵斜隔膜。根据形态特征, 初步鉴定为麦根腐平脐蠕孢(Bipolaris sorokiniana)。
菌株OL-6(图3J~L)生长速度缓慢, 生长7 d后, 菌落平铺, 直径约32 mm, 表面绒状, 整体呈绿色, 边缘较整齐, 中央有放射状纹理, 背面黑绿色。 分生孢子链生, 长圆形、卵圆形或长椭圆形, 灰色至灰黄色, 大小为(4.5~22.4) μ m× (2.3~7.8) μ m。无或有1个隔膜。根据形态特征, 初步鉴定为多主枝孢(Cladosporium herbarum)。
菌株OL-7(图3M~O)生长速度快, 生长7 d后, 菌落平铺, 近似圆形, 直径约68 mm, 表面粗绒状, 中央浅棕色至棕色, 边缘较整齐, 呈乳白色, 背面中央黑褐色, 边缘乳白色。分生孢子圆柱形, 褐色至黄褐色, 大小为(10.52~32.47) μ m× (3.24~9.63) μ m, 横隔3~7个。根据形态特征, 初步鉴定为燕麦内脐蠕孢(Drechslera avenae)。
从病原菌OL-1~OL-10中提取DNA, 用真菌ITS基因通用引物ITS1和ITS4进行PCR扩增, 获得520 bp左右的特异性rDNA-ITS片段。将测序获得的序列登录NCBI网站, 在GenBank数据库中进行Blast同源性比对, 发现10个菌株的rDNA-ITS序列同已知物种的同源序列相似性均在98%以上。进一步采用MEGA 7.0软件对10个病原菌的序列与下载的参考菌株序列进行系统发育树分析(图4), 结果表明菌株OL-1~OL-10的基因序列分别与细交链格孢、芸薹链格孢、苹果链格孢、麦根腐平脐蠕孢、芽枝状枝孢菌、多主枝孢、燕麦内脐蠕孢、黑附球菌、燕麦核腔菌和德氏霉菌的进化距离较近, 聚为一支。结合其形态学特征, 将病原菌OL-1~OL-10依次鉴定为细交链格孢、芸薹链格孢、苹果链格孢、麦根腐平脐蠕孢、芽枝状枝孢菌、多主枝孢、燕麦内脐蠕孢、黑附球菌、燕麦核腔菌和德氏霉菌。
从供试材料中共分离得到5属10种病原菌(表3), 分别为链格孢属的细交链格孢、芸薹链格孢和苹果链格孢; 离蠕孢属的麦根腐平脐蠕孢; 枝孢菌属的芽枝状枝孢菌和多主枝孢; 德氏霉属的燕麦内脐蠕孢、燕麦核腔菌和德氏霉菌; 附球菌属的黑附球菌。不同供试样品所携带的病原菌种类和数量不同, 从各样品可分离出的病原菌种类为3~9种, 1号样品分离到的病原菌种类最多, 为9种; 其次是2、4、9和10号样品, 均分离出6种; 5、6和7号样品分离出的病原菌最少, 仅有3种。各供试样品均可分离出细交链格孢和燕麦内脐蠕孢, 芸薹链格孢、燕麦核腔菌和德氏霉菌可从大多数材料中分离到, 其他病原菌仅能从2~3份样品中分离出。另外, 同一品种在不同调查区域分离到的病原菌不同, 白燕7号在定西市通渭县华家岭镇老站村分离到病原菌9种(1号样品), 从张掖市山丹县马营乡军马二场分离出6种(4号样品), 其共同携带的病原菌为细交链格孢、芸薹链格孢、芽枝状枝孢菌、多主枝孢、燕麦内脐蠕孢和燕麦核腔菌, 而麦根腐平脐蠕孢、黑附球菌和德氏霉菌仅在1号样品中检出。
| 表3 不同供试样品病原菌分离情况 Table 3 Separation of pathogens from different test samples |
植物在自然生长过程中都会受到病害的侵染, 二者间的相互作用是一个复杂的生物学过程[21]。黄凌洪等[22]研究表明, 水稻(Oryza sativa)稻瘟病的发生主要跟植株自身的抗病能力、农业管理制度、病原菌的存活力以及致病性差异有关。赵峰等[23]认为燕麦病害的发生是一个复杂的过程, 并不是由某一因素起决定性作用, 而是由植物本身抗病基因的调控能力、当地的气候条件和农业种植环境等多种因素共同作用的结果。李彦忠等[17]在红豆草(Onobrychis vicicaefolia)上的研究表明, 同一病害在不同地区的发病率差异显著, 其中红豆草黑秆病在渭源县和榆中县的发病率(分别为62.7%, 89.7%)均显著高于通渭县(21.9%)。与之相比, 红豆草茎点霉叶斑病在通渭县发病率最高(66.9%); 在渭源县最低(23.7%)。孙雪梅[15]对山西右玉县、河北张北县、内蒙古武川县和乌兰察布市的燕麦叶斑病调查发现, 发病最重的是内蒙古乌兰察布市的草莜1号, 病情指数高达60.31; 而山西右玉县的白燕2号未发病。白燕2号在河北张北县发病最严重, 病情指数56.42; 而在其他调查地区的发病较轻, 病情指数低于1.50。本研究也得到类似结果, 甘肃省5个燕麦主要种植区主栽品种的叶斑病发生情况差异显著, 病叶率为5.46%~99.61%, 病情指数为1.36~71.08。同一燕麦品种在不同地区的发病情况不同, 如白燕7号在定西市通渭县华家岭镇老站村发病较严重(病叶率98.67%, 病情指数71.08), 而在张掖市山丹县马营乡军马二场发病相对较轻(34.53%, 10.53)。不同品种在同一地区的叶斑病发生程度也存在差异, 如张掖市山丹县马营乡军马二场牧乐思的病叶率和病情指数都显著低于白燕7号; 甘南州合作市卡加曼乡香拉村的贝勒和加燕2号的病叶率相近, 但前者的病情指数明显高于后者。
在真菌鉴定方面, 传统纯培养等检测方法耗时长、效率低、限制因素多, 而结合真菌致病性检测和rDNA-ITS分子生物学鉴定对病原菌进行鉴定, 具有特异性强、准确性高和操作简便等优势, 并能客观体现真菌种群关系、亲缘关系以及反应菌株的系统发育规律, 可对病原菌进行快速鉴定和准确分类[24, 25]。陈姗姗等[26]通过致病性鉴定、形态学鉴定和rDNA-ITS序列分析, 发现引起黄连根腐病的病原菌为腐皮镰孢菌(Fusarium solani)。郭宁等[27]通过病原菌的分离培养、致病性测定、形态特征观察及rDNA-ITS分子鉴定, 证明引起玉米(Zea mays)叶斑病的病原菌是麦根腐平脐蠕孢。本研究除对感染叶斑病的病原组织中分离到的多株菌株进行致病性鉴定外, 还进一步进行了形态学鉴定以及rDNA-ITS序列分析, 结果表明, 引起甘肃省燕麦主产区叶斑病的病原菌有5属10种。目前, 我国对由细交链格孢、麦根腐平脐蠕孢、苹果链格孢等真菌引起的叶斑病害在其他植物上已多有报道[28, 29, 30, 31], 但有关引起燕麦叶斑病的病原菌目前国内外报道的只有燕麦内脐蠕孢、燕麦核腔菌、德氏霉菌和禾旋孢腔菌, 因此, 本研究新发现的链格孢属的细交链格孢、芸薹链格孢和苹果链格孢, 枝孢菌属的芽枝状枝孢菌和多主枝孢, 离蠕孢属的麦根腐平脐蠕孢以及附球菌属的黑附球菌均为燕麦叶斑病新的致病菌。
从各调查区域的样品中分离到的病原菌为3~9种, 其中从定西市通渭县华家岭镇老站村的白燕7号样品中分离到的病原菌最多, 为9种; 张掖市民乐县南丰乡炒面庄村的加拿大北燕麦、玉麦子以及武威市天祝县松山镇黑马圈河村的甜燕麦样品中分离出的病原菌种最少, 仅有3种。在不同调查区域从同一品种分离到的病原菌不同, 在定西市通渭县华家岭镇老站村的白燕7号样品中分离到病原菌9种, 在张掖市山丹县马营乡军马二场的分离出6种, 其中麦根腐平脐蠕孢、黑附球菌和德氏霉菌仅存在于华家岭镇老站村的白燕7号样品中。这与曾益春等[32]对桑葚菌核病的研究结果类似。不同地理环境下, 病害发生和流行的温度和湿度不同, 致病菌的种类和发生情况就会有差异[33, 34]。王亚荣等[35]对海南省马槟榔炭疽病研究表明, 该病在天气干燥和潮湿时的病症表现不同, 空气湿度较大时, 病斑上易产生分生孢子堆且较粘, 推测该病的发生情况与当地旱季和雨季分明有关。有研究表明, 燕麦叶斑病病原孢子的萌发和繁殖多发生在潮湿的环境条件下, 其中低温高湿是引发该病害的主要因素[36]。因此, 可在燕麦植株的生长阶段做好旱季和雨季的防御工作, 以减轻燕麦叶斑病的发生和引起的危害。
本研究从各参试材料中均分离出了细交链格孢和燕麦内脐蠕孢, 芸薹链格孢、燕麦核腔菌和德氏霉菌也可从绝大多数材料中检出, 说明这些病原菌对燕麦的侵染能力较强, 侵染范围较广, 很可能是甘肃省燕麦叶斑病的主要致病菌。链格孢属[37, 38, 39]和德氏霉属[40, 41, 42]等真菌的寄生能力较强, 寄主范围较广, 某些具有致病性的真菌可影响植物正常的生长发育和生理代谢, 引起作物减产和品质下降, 造成较大的经济损失。前人研究表明, 有效防控病害的举措除明确其致病菌外, 还需对该病原菌的发生流行规律、传播途径、发病条件及防治措施等方面进行研究, 以科学防控该病害[43, 44]。因此, 还需对这些病原菌在燕麦植株上的病害流行规律、致病机理及防治措施等做进一步的研究, 从而保障燕麦产业的健康稳定发展。
燕麦叶斑病在甘肃省燕麦主产区普遍发生, 同一品种在不同种植区的叶斑病发生情况明显不同, 不同品种在同一种植区的表现也有显著差异。定西市通渭县叶斑病发病最严重, 张掖市民乐县发病最轻。引起甘肃省燕麦叶斑病的病原菌有5属10种。除燕麦内脐蠕孢和燕麦核腔菌外, 细交链格孢、芸薹链格孢、苹果链格孢、麦根腐平脐蠕孢、黑附球菌、芽枝状枝孢菌、多主枝孢和德氏霉菌均为国内首次发现和报道。
| [1] |
|
| [2] |
|
| [3] |
|
| [4] |
|
| [5] |
|
| [6] |
|
| [7] |
|
| [8] |
|
| [9] |
|
| [10] |
|
| [11] |
|
| [12] |
|
| [13] |
|
| [14] |
|
| [15] |
|
| [16] |
|
| [17] |
|
| [18] |
|
| [19] |
|
| [20] |
|
| [21] |
|
| [22] |
|
| [23] |
|
| [24] |
|
| [25] |
|
| [26] |
|
| [27] |
|
| [28] |
|
| [29] |
|
| [30] |
|
| [31] |
|
| [32] |
|
| [33] |
|
| [34] |
|
| [35] |
|
| [36] |
|
| [37] |
|
| [38] |
|
| [39] |
|
| [40] |
|
| [41] |
|
| [42] |
|
| [43] |
|
| [44] |
|